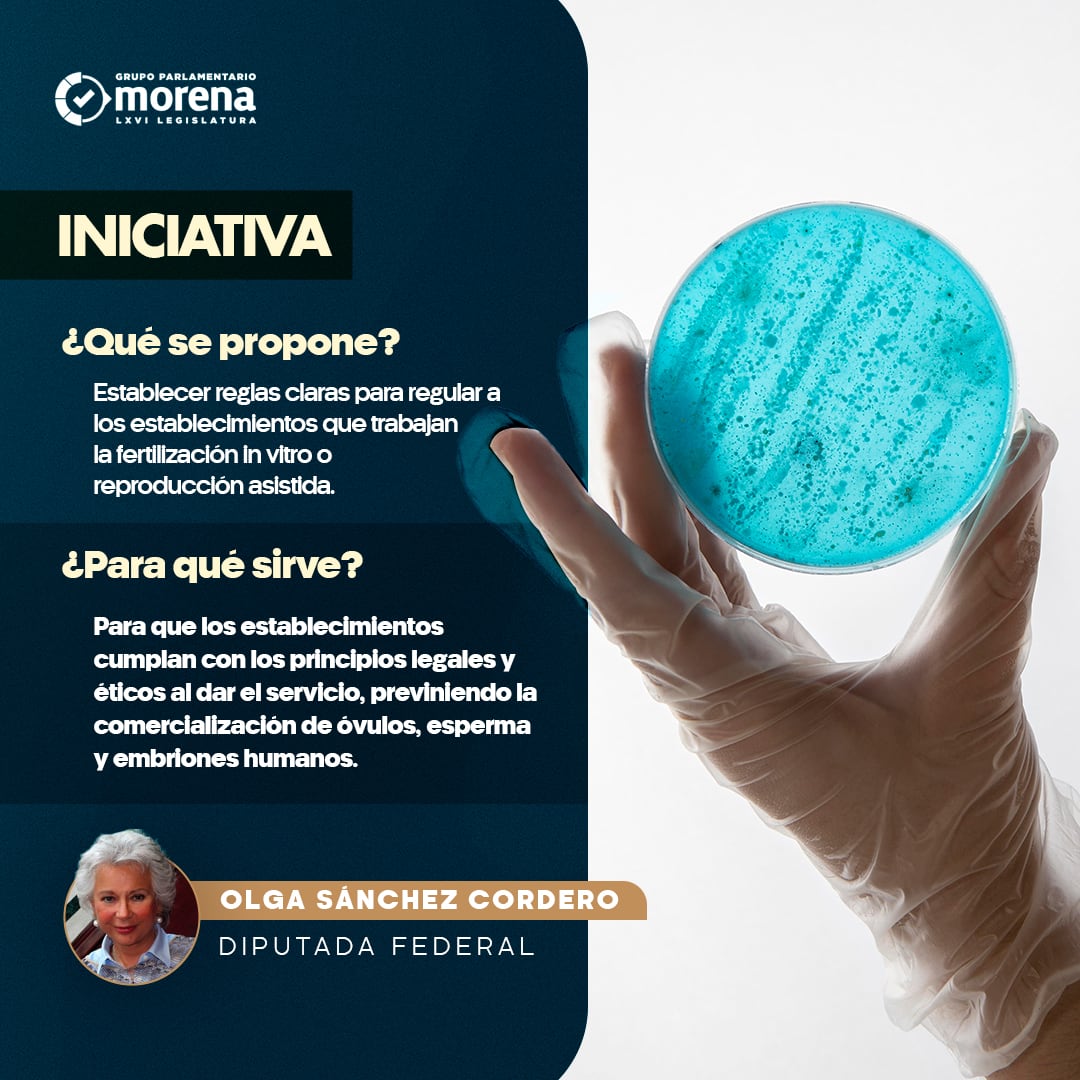

La ex secretaria de Gobernación y ministra en retiro, Olga Sánchez Cordero presentó en la Cámara de Diputados una iniciativa para regular los servicios de fertilidad; te decimos de qué se trata a detalle.
De acuerdo con un boletín de 2017 del Instituto Mexicano del Seguro Social (IMSS), atendía a un promedio de 12 mil parejas con problemas de infertilidad al año y solamente en la Unidad de Biología de la Reproducción del Hospital de Gineco Obstetricia de La Raza.
Sin embargo, la Organización Mundial de la Salud (OMS) señaló que el problema de infertilidad aumentó un 40% en la última década, debido a diferentes problemas que también conllevan a una baja probabilidad de embarazarse con servicios de fertilidad.






Olga Sánchez Cordero presenta iniciativa para regular servicios de fertilidad; te decimos de qué se trata
La iniciativa de Olga Sánchez Cordero busca establecer reglas claras para regular los establecimientos que trabajan la fertilización in vitro, también conocida como reproducción asistida, para que cumplan con principios legales y éticos en su servicio.
Tiene como objetivo que los servicios de infertilidad no comercialice con óvulos, espermas o embriones humanos, debido al mercado negro de células humanas, por lo que Olga Sánchez Cordero propone la iniciativa para defender el derecho a la familia.
La iniciativa de Olga Sánchez Cordero busca reformar la Ley General de Salud, en materia de reproducción asistida, exactamente los siguientes artículos:
- fracción V del artículo 3
- fracción VIII del 17 Bis
- fracciones IV y V del 313 y se adiciona la fracción VI
- fracciones XXVII y XXVIII del 314, más la fracción XXIX
- artículo 373
- artículo 462, más la adición de la fracción VIII
- fracciones I, II, III, IV y último párrafo del 466
- se adiciona el Capítulo VI Bis Reproducción Asistida, con los artículos
- 71 Bis
- 71 Bis 2
- 71 Bis 3
- 71 Bis 4
- 71 Bis 5
- se adiciona el artículo 421 Quáter
Por lo mismo, la iniciativa de Olga Sánchez Cordero menciona que se agregue la reproducción asistida en los artículos anteriores además de que se deben vigilar las células de seres humanos para evitar el mercado negro.
Esto dijo Olga Sánchez Cordero en la Cámara de Diputados sobre iniciativa para regular servicios de fertilidad
Como ya se mencionó, Olga Sánchez Cordero presentó la iniciativa para regular los servicios de fertilidad en el Pleno de la Cámara de Diputados, la cual fue turnada a la Comisión de Salud sin fecha de discusión.
Durante su ponencia, Olga Sánchez Cordero recalcó que la infertilidad es un problema de salud que afecta a cientos de miles de personas en México, lo que representa un reto para las personas que buscan una familia bajo varios riesgos.
Citando datos ante la Cámara de Diputados, Olga Sánchez Cordero mencionó que en México existían en 2013, 52 servicios de fertilidad autorizados, aunque podría haber más de 100 que funcionarían sin estar regulados.
En su exposición de motivos, Olga Sánchez Cordero señala que la iniciativa de servicios de fertilidad busca que el Estado garantice el derecho a la familia, mediante la reproducción asistida ante el incremento de infertilidad debido a diversos factores:
- trastornos de las trompas uterinas
- un trastorno uterino
- trastorno ovárico
- o del sistema endocrino
- obstrucción por disfunción en la emisión del semen
- trastornos hormonales
- insuficiencia testicular
- deficiencias en la calidad del esperma
- régimen de vida como tabaquismo o alcoholismo
- exposición a contaminantes
Por lo mismo, las personas ponen en riesgo su vida al buscar la reproducción asistida en servicios de fertilidad sin apego a las regulaciones o los estándares médicos y éticos, jugando con el anhelo de buscar una familia.



